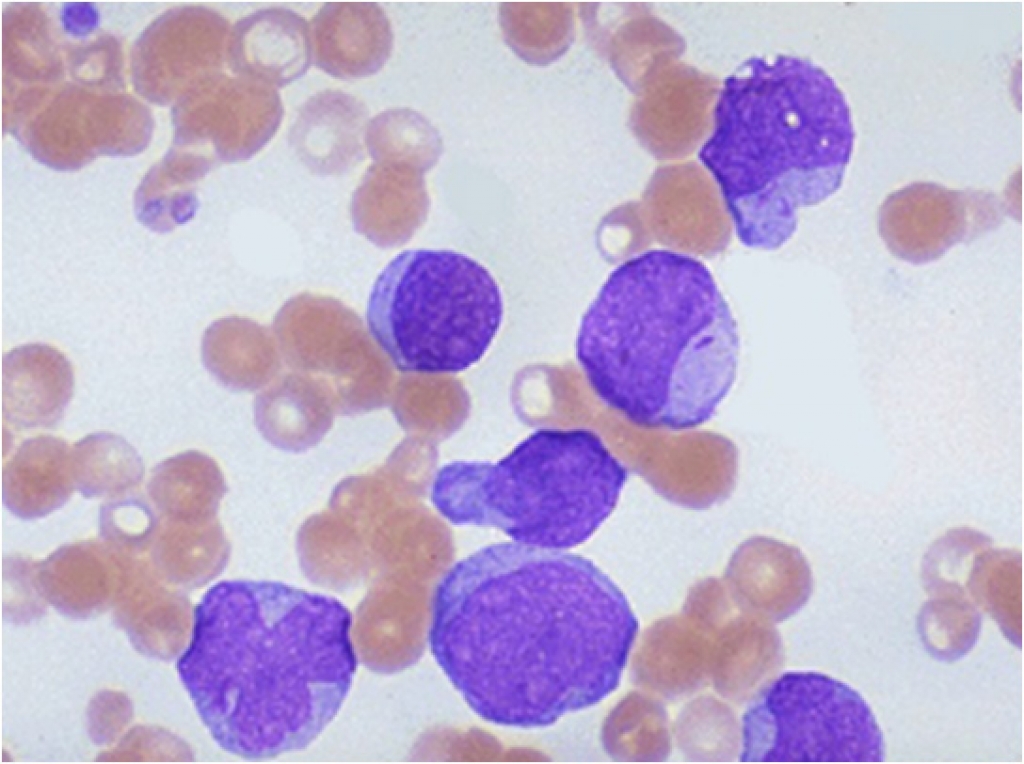

Переливание при лейкозе
Переливание при лейкозе 101 фото
Как чувствует боярский
Человек паук вернулся домой
Антенна w124
Самоцветы фигурное катание
Суббота картинки прикольные для поднятия настроения доброе
Комбинированные приемы тепловой обработки
Гипермаркет виват пермь
Feso4 основание и кислота
Jamis trail x отзывы
Вакансии воронежского правительства